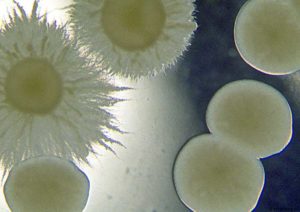

Згідно зі статистичними даними, кожна друга вагітна жінка стикається з таким захворюванням, як молочниця. Це особливий грибок роду candida, офіційна назва недуги — кандидоз.
Зміст
Молочниця при вагітності: як можна вилікувати недугу
 Молочниця є дуже поширеним захворюванням.
Молочниця є дуже поширеним захворюванням.
Жінки ігнорують симптоми, з-за чого лікування не відбувається, хвороба набуває хронічну форму.
Особливу небезпеку молочниця тягне під час виношування дитини.
Що таке грибок Кандида при вагітності
Молочниця — народна назва захворювання. Основними симптомами захворювання є виділення, схожі по консистенції на скисле молоко. При цьому жінка відчуває дискомфорт, печіння, іноді неприємні хворобливі відчуття в області піхви. Лікарі називають це захворювання кандидозом або кандидозным кульпітом. Згідно зі статистикою, приблизно половина всіх захворювань статевих шляхів припадає саме на кандидоз.
 У 35% випадків вперше з захворюванням стикаються саме будучи в положенні.
У 35% випадків вперше з захворюванням стикаються саме будучи в положенні.
Причини появи
 В організмі кожної жінки цей грибок в певних кількостях присутній. За цим «стежать» вагінальні бактерії. Разом вони складають нормальну мікрофлору. При певних обставинах корисні бактерії гинуть, захисна функція організму послаблюється, розмножуються гриби. Кандидоз — ознака зниженого імунітету, тому він вкрай небезпечний під час вагітності.
В організмі кожної жінки цей грибок в певних кількостях присутній. За цим «стежать» вагінальні бактерії. Разом вони складають нормальну мікрофлору. При певних обставинах корисні бактерії гинуть, захисна функція організму послаблюється, розмножуються гриби. Кандидоз — ознака зниженого імунітету, тому він вкрай небезпечний під час вагітності.
Захворювання говорить про наявність в організмі інфекції, зокрема прихованою, наприклад хламідіозу, мікоплазмозу та інших. Також причиною молочниці є: тривалий прийом антибіотиків (вони вбивають живі корисні бактерії), гормональних препаратів, зміни кислотності піхвового середовища, неправильне харчування, сильні стреси і переживання, безсоння, погана навколишнє середовище і багато іншого.
На ранніх термінах до затримки місячних
Молочниця загострюється відразу після настання овуляції, через кілька днів. Це відбувається в тому циклі, коли трапляється вагітність. Як правило, жінки не підозрюють про неї, і починають лікування. Робити це не рекомендується, оскільки велика ймовірність загибелі ембріона.
 При появі перших ознак молочниці слід звернутися до гінеколога. Варто попередити лікаря про можливу вагітність.
При появі перших ознак молочниці слід звернутися до гінеколога. Варто попередити лікаря про можливу вагітність.
У другому триместрі
 Кандидоз часто загострюється у другому триместрі вагітності. Причиною тому служить ослаблений імунітет. До появи недуги призводить зміна гормонального фону.
Кандидоз часто загострюється у другому триместрі вагітності. Причиною тому служить ослаблений імунітет. До появи недуги призводить зміна гормонального фону.
Слизові піхви і вульви стають набряклими, пухкими, підвищується температура, посилюється кровотік. Це ідеальне середовище для розмноження бактерій. У цей період організм жінки повинен отримувати велику кількість позитивних емоцій. Раціон повинен включати всі корисні речовини і вітаміни. Більше часу слід проводити на свіжому повітрі.
У 3 триместрі
Більшість ресурсів організму в цей період вагітності йде на розвиток плоду. Майбутня мама набирає у вазі, це негативно позначається на психоемоційному стані. Організм недоотримує подезных речовин, слабшає. Третій триместр вагітності — період, коли жінок часто мучить безсоння, вона переживає про майбутні пологи. У сукупності це є причиною загострення кандидозу.
Симптоми прояву при вагітності на різних термінах
Молочниця на різних термінах вагітності проявляється однаково, причому симптоми вагітних ніяк не відрізняються від симптомів, які виявляються у невагітних жінок. Основними є:
Молочниця на різних термінах вагітності проявляється однаково, причому симптоми вагітних ніяк не відрізняються від симптомів, які виявляються у невагітних жінок. Основними є:
- рясні творожистие або водянисті виділення з піхви — мають білий, рідше жовтий колір;
- свербіж і печіння в піхву і зовнішніх статевих органів — ці відчуття настільки неприємні, що змушують жінку не думати ні про що іншому;
- почервоніння, набряк статевих органів — це трапляється через подразнення, які виділяються з піхви і промежини;
- хворобливий статевий акт;
- неприємний запах — різкий запах не притаманний даному захворюванню, однак при рясних виділеннях жінка відчуває кислий запах.
Може протікати безсимптомно
Вкрай рідко жінки здають аналізи при відсутності будь-яких скарг. Згідно зі статистикою з кандидозом стикається кожна третя вагітна жінка. Багато хто при цьому і не підозрювали у себе наявність недуги, не відчували жодних симптомів. Якщо лікар після збору аналізів виявляє наявність грибка, це говорить про те, що людина є носієм захворювання і активізується грибок в будь-який момент.
 При виявленні в лабораторному аналізі грибка, його варто лікувати так само, як якщо б молочниця прийняла гостру форму.
При виявленні в лабораторному аналізі грибка, його варто лікувати так само, як якщо б молочниця прийняла гостру форму.
Види молочниці при вагітності
 Видів молочниці на сьогоднішній день існує безліч. Найбільш поширеними серед вагітних є три форми молочниці:
Видів молочниці на сьогоднішній день існує безліч. Найбільш поширеними серед вагітних є три форми молочниці:
- жінка — носій кандидозу. Пацієнтка не має скарг, грибок виявляється при здачі аналізу;
- гострий кандидоз. Жінка скаржиться на наявність свербіння і печіння при цьому відчуває дискомфорт протягом тривалого часу; з’являються рясні виділення, свербіж, печіння;
- хронічний кандидоз — ускладнена молочниця, яка розвивається і триває більше 2 місяців.
Чим небезпечна хронічна молочниця для вагітності
Хронічна форма молочниці дуже небезпечна для жінки і негативно позначається на майбутній дитині. Хронічний кандидоз впливає на перебіг вагітності, еластичність піхви втрачається, розвивається ерозії матки, велика ймовірність розривів під час пологів.
Як впливає Кандида на дитину
 Хронічна форма кандидозу негативно впливає на дитину.
Хронічна форма кандидозу негативно впливає на дитину.
Молочниця сприяє:
- затримки розвитку плода;
- зупинки росту плода:
- порушення кровотоку;
- внутрішньоутробного зараження;
- кисневого голодування.
Як лікують вагінальний кандидоз у вагітних жінок медикаментозно
Сьогодні існує величезна кількість препаратів, здатних позбутися жінку від молочниці. Щоб результат був максимально ефективним, необхідно проходити терапію курсом, більш того, необхідно лікувати і чоловіка.
 Призначати будь-який медичний препарат під час вагітності жінки повинен лікар.
Призначати будь-який медичний препарат під час вагітності жінки повинен лікар.
1 триместр лікування таблетками
У першому триместрі вагітності лікарі рекомендують використовувати засіб, який безпечно як для жінки, так і для дитини — свічки Пімафуцин. Їх необхідно застосовувати згідно з інструкцією або за індивідуальним призначенням лікаря.
2 триместр лікування
 У другому триместрі вагітності краще застосовувати капсули та супозиторії, наприклад Поліжінакс. Містить в складі ністатин і неомици, володіє протигрибковою антибактеріальною дією. Зазвичай призначають курсом 10-12 днів.
У другому триместрі вагітності краще застосовувати капсули та супозиторії, наприклад Поліжінакс. Містить в складі ністатин і неомици, володіє протигрибковою антибактеріальною дією. Зазвичай призначають курсом 10-12 днів.
3 триместр лікування
У третьому триместрі вагітним призначають вагінальні таблетки Клотримазол. Вони відмінно діє на грибок, позбавляючи жінку від недуги. Вводити потрібно два рази на добу протягом 3 днів.
Коли лікують перед пологами
При виявленні молочниці перед пологами лікар рекомендує використовувати одноразово свічку Залаин. Вона безпечна для жінки і плоду, її можна застосовувати на будь-якому терміні вагітності.
Лікування народними засобами
 Кандидоз під час вагітності також можна лікувати, використовуючи народні методи, як правило, у першому триместрі жінки виконують ванночки. Для їх приготування необхідно взяти 2 л води, додати ложку соди, кілька крапель йоду. Виконувати такі процедури рекомендується не менше 2 тижнів.
Кандидоз під час вагітності також можна лікувати, використовуючи народні методи, як правило, у першому триместрі жінки виконують ванночки. Для їх приготування необхідно взяти 2 л води, додати ложку соди, кілька крапель йоду. Виконувати такі процедури рекомендується не менше 2 тижнів.
Також відмінним народним засобом проти молочниці є тампони, просочені кефіром. Їх необхідно вставляти в піхву на годину-півтора, курс лікування становить два тижні. Гінекологи рекомендують підмиватися відваром з трав. Він повинен бути свіжоприготованим. Для виготовлення необхідно використовувати квіти ромашки, залити їх окропом і настоювати протягом 20 хвилин, після чого можна застосовувати.
Що можна приймати
Вагітним жінкам при виявленні молочниці лікар призначає курс прийому антибактеріальних препаратів: таблетки, свічки або різні капсули. Сучасні засоби по боротьбі з недугою здатні позбавити від нього в найкоротші терміни.
 Приймати препарати проти кандидозу необхідно суворо за призначенням гінеколога.
Приймати препарати проти кандидозу необхідно суворо за призначенням гінеколога.
Чим небезпечний candida albicans при пологах
 Лікарі рекомендують вилікувати кандидоз до пологів, в іншому випадку збільшується ризик інфікування малюка. Це може бути як внутрішньоутробно, так і під час пологів. Молочниця найбільш небезпечна саме перед пологами або в самому процесі, коли пробка відходить від плоду. Грибок проходить через цервікальний канал, малюк стає інфікованим. Новонароджені страждають стоматитом, він проявляється через кілька днів після народження і являє собою білий наліт у роті. Молочниця причина складнощів із зором у дитини, велика ймовірність ураження внутрішніх органів, розвиток кандидозу статевих органів у малюка.
Лікарі рекомендують вилікувати кандидоз до пологів, в іншому випадку збільшується ризик інфікування малюка. Це може бути як внутрішньоутробно, так і під час пологів. Молочниця найбільш небезпечна саме перед пологами або в самому процесі, коли пробка відходить від плоду. Грибок проходить через цервікальний канал, малюк стає інфікованим. Новонароджені страждають стоматитом, він проявляється через кілька днів після народження і являє собою білий наліт у роті. Молочниця причина складнощів із зором у дитини, велика ймовірність ураження внутрішніх органів, розвиток кандидозу статевих органів у малюка.
Для жінки наявність молочниці під час пологів вкрай небезпечно, особливо у випадку кесаревого розтину. Наявність кандидозу провокує ризик розвитку сепсису.
 Молочниця уповільнює процес гоєння післяпологових швів. Розвиваються запалення і нагноєння. У 95% випадків жінці потрібна комплексна антибактеріальна терапія.
Молочниця уповільнює процес гоєння післяпологових швів. Розвиваються запалення і нагноєння. У 95% випадків жінці потрібна комплексна антибактеріальна терапія.
З яких причин з’являється молочниця перед пологами
Всі дев’ять місяців вагітності жіночий організм піддається різним факторам, в ньому спостерігаються кардинальні зміни, які впливають на харчові пристрасті, гормональний фон і імунну систему. Природно в такому стані грибок, який є у кожної людини, збільшується в чисельності. Він є причиною неприємних симптомів таких як білі творожистие виділення, неприємний свербіж і печіння. Дане захворювання тягне за собою масу неприємних наслідків.
Харчування
 Наявність молочниці передбачає обмеження у вживанні певних продуктів, наприклад, варто відмовитися від цукру, прянощів, гострої, жирної їжі, алкоголю і грибів. Лікарі-гінекологи стверджують, що одужання від кандидозу сприяють наступні продукти:
Наявність молочниці передбачає обмеження у вживанні певних продуктів, наприклад, варто відмовитися від цукру, прянощів, гострої, жирної їжі, алкоголю і грибів. Лікарі-гінекологи стверджують, що одужання від кандидозу сприяють наступні продукти:
- свіжі овочі;
- несолодкі фрукти;
- бобові;
- нежирне м’ясо;
- яйця;
- риба;
- печінка;
- морепродукти та ін.
Молочницю можна і потрібно лікувати вчасно, інакше велика вірогідність серйозних наслідків при виношуванні дитини. Головне вчасно звернутися за допомогою до гінеколога. Тільки він здатний призначити правильні, можна розв’язати до застосування препарати.
Щоб уникнути повторної появи молочниці необхідно виконувати ряд певних правил: дотримуватися правил особистої гігієни, їсти лише корисні продукти, не нервувати, приймати вітаміни, не перезавантажувати себе фізично, вчасно лікувати різні захворювання, контролювати рівень гормонів.


